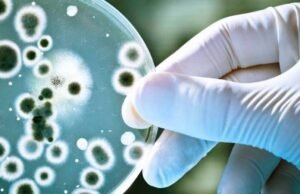
Salud Pública confirma cuatro casos de difteria, entre ellos un deceso

Redacción
Director de Migración estudiará proyecto de ley Trata de Personas y...
Santo Domingo.- El Director General de Migración Venancio Alcántara, dijo que analizará en toda su dimensión el proyecto de Ley Integral sobre Trata de...
DNCD captura en SPM hombre buscado por narcotráfico en EUA
Santo Domingo.- La Dirección Nacional de Control de Drogas (DNCD) y miembros del Ministerio Público, apoyados por el Servicio de Alguaciles de Estados Unidos,...
Banco Central y AIRD evalúan el comportamiento de la economía dominicana
Economía.- El gobernador del Banco Central de la República Dominicana (BCRD), Héctor Valdez Albizu, mantuvo un encuentro con la nueva directiva de la Asociación...
LatinFinance reconoce el manejo de deuda del Gobierno dominicano
Santo Domingo.- Dos de las exitosas operaciones de manejo de pasivos realizadas por la actual administración del Ministerio de Hacienda, que le permitieron al...
Twitter amplía el límite de caracteres para sus clientes de pago...
Tecnología.- Twitter anunció este miércoles que amplía el límite de caracteres para los suscriptores de su servicio de pago Twitter Blue en EE.UU. con...
Salud Pública confirma cuatro casos de difteria, entre ellos un deceso
Santo Domingo.- Cuatro casos de difteria se han confirmado este año en la República Dominicana, entre ellos un fallecimiento, informó este miércoles el Ministerio...
¡Azúcar! EEUU pondrá la cara de Celia Cruz en monedas de...
Espectáculos.- El rostro de la legendaria cubana Celia Cruz, o la «Guarachera de Cuba» como muchos la conocen, estará plasmado en una moneda de 25 centavos de Estados...
Inglaterra registra el mayor número de homicidios con arma blanca desde...
Internacionales.- La región de Inglaterra, la más poblada del Reino Unido, y Gales, en la misma jurisdicción administrativa, registró en el ejercicio 2021/22 su...
Eddy Olivares asegura al PRM no le preocupa alianza electoral opositora
Política.- El vicepresidente del gobernante Partido Revolucionario Moderno, Eddy Olivares, afirmó que a esa organización poco le preocupa los acercamientos que hacen los partidos...
Pareja de La Guáyiga fue torturada antes de ser asesinada con...
Santo Domingo.- El Ministerio Público en Santo Domingo Oeste continúa las investigaciones en torno a la pareja de esposos que fue encontrada sin vida...